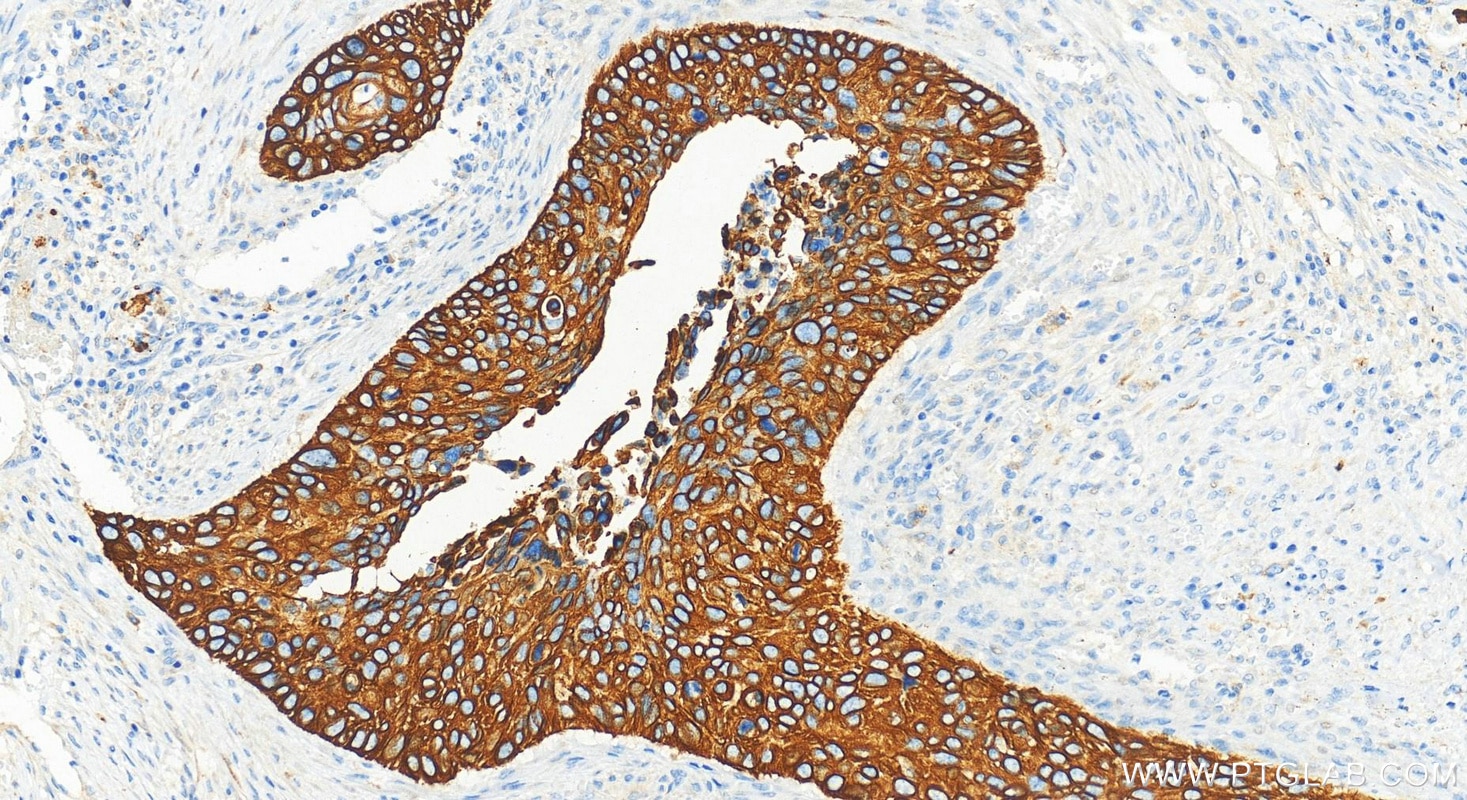

Tested Applications
| Positive WB detected in | A431 cells, HeLa cells, HaCaT cells, mouse skin tissue, rat skin tissue |
| Positive IP detected in | A431 cells |
| Positive IHC detected in | human cervical squamous cancer tissue, human bowen disease tissue, human lung squamous cell carcinoma tissue Note: suggested antigen retrieval with TE buffer pH 9.0; (*) Alternatively, antigen retrieval may be performed with citrate buffer pH 6.0 |
| Positive IF/ICC detected in | HepG2 cells, HeLa cells |
Recommended dilution
| Application | Dilution |
|---|---|
| Western Blot (WB) | WB : 1:1000-1:20000 |
| Immunoprecipitation (IP) | IP : 0.5-4.0 ug for 1.0-3.0 mg of total protein lysate |
| Immunohistochemistry (IHC) | IHC : 1:4000-1:16000 |
| Immunofluorescence (IF)/ICC | IF/ICC : 1:300-1:1200 |
| It is recommended that this reagent should be titrated in each testing system to obtain optimal results. | |
| Sample-dependent, Check data in validation data gallery. | |
Published Applications
| KD/KO | See 3 publications below |
| WB | See 16 publications below |
| IHC | See 12 publications below |
| IF | See 8 publications below |
| CoIP | See 1 publications below |
Product Information
17516-1-AP targets Cytokeratin 17-Specific in WB, IHC, IF/ICC, IP, CoIP, ELISA applications and shows reactivity with human, mouse, rat samples.
| Tested Reactivity | human, mouse, rat |
| Cited Reactivity | human, mouse |
| Host / Isotype | Rabbit / IgG |
| Class | Polyclonal |
| Type | Antibody |
| Immunogen |
Peptide Predict reactive species |
| Full Name | keratin 17 |
| Calculated Molecular Weight | 48 kDa |
| Observed Molecular Weight | 48 kDa |
| GenBank Accession Number | NM_000422 |
| Gene Symbol | Cytokeratin 17 |
| Gene ID (NCBI) | 3872 |
| RRID | AB_2133036 |
| Conjugate | Unconjugated |
| Form | Liquid |
| Purification Method | Antigen affinity purification |
| UNIPROT ID | Q04695 |
| Storage Buffer | PBS with 0.02% sodium azide and 50% glycerol, pH 7.3. |
| Storage Conditions | Store at -20°C. Stable for one year after shipment. Aliquoting is unnecessary for -20oC storage. 20ul sizes contain 0.1% BSA. |
Background Information
Keratins are a large family of proteins that form the intermediate filament cytoskeleton of epithelial cells, which are classified into two major sequence types. Type I keratins are a group of acidic intermediate filament proteins, including K9-K23, and the hair keratins Ha1-Ha8. Type II keratins are the basic or neutral courterparts to the acidic type I keratins, including K1-K8, and the hair keratins, Hb1-Hb6. Keratin 17 is a type I cytokeratin. It is found in nail beds, hair follicles, sebaceous glands, and other epidermal appendages. It is used as a marker for trauma. This antibody is specifically against KRT17.
Protocols
| Product Specific Protocols | |
|---|---|
| IF protocol for Cytokeratin 17-Specific antibody 17516-1-AP | Download protocol |
| IHC protocol for Cytokeratin 17-Specific antibody 17516-1-AP | Download protocol |
| IP protocol for Cytokeratin 17-Specific antibody 17516-1-AP | Download protocol |
| WB protocol for Cytokeratin 17-Specific antibody 17516-1-AP | Download protocol |
| Standard Protocols | |
|---|---|
| Click here to view our Standard Protocols |
Publications
| Species | Application | Title |
|---|---|---|
Clin Cancer Res A Preclinical Trial and Molecularly Annotated Patient Cohort Identify Predictive Biomarkers in Homologous Recombination-deficient Pancreatic Cancer. | ||
Breast Cancer Res Anillin regulates breast cancer cell migration, growth, and metastasis by non-canonical mechanisms involving control of cell stemness and differentiation. | ||
Oncogene The keratin 17/YAP/IL6 axis contributes to E-cadherin loss and aggressiveness of diffuse gastric cancer
| ||
Phytother Res Epigallocatechin-3-gallate promotes wound healing response in diabetic mice by activating keratinocytes and promoting re-epithelialization | ||
J Invest Dermatol Keratin 17 Impacts Global Gene Expression and Controls G2/M Cell Cycle Transition in Ionizing Radiation-Induced Skin Damage |
Reviews
The reviews below have been submitted by verified Proteintech customers who received an incentive for providing their feedback.
FH Lindsey (Verified Customer) (08-08-2025) | This antibody works very well on both FFPE tissue (with heat based citrate buffer antigen retrieval) and whole mount embryonic skin. It is highly specific based on our experience and can be used from 1/1000 to 1/1200 dilution (1/1000 for adult and 1/1200 for embryonic).
|